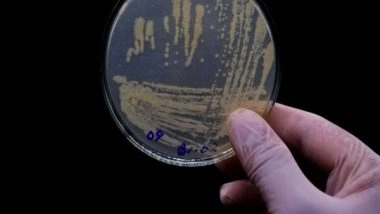
Health News | New Research Reveals Relationship Between Oral Bacteria and Diseases

Stockholm [Sweden], November 24 (ANI): The bacteria most frequently seen in severe mouth infections have been identified by researchers at Sweden's Karolinska Institutet. There haven't been many studies of this kind, so the team is hoping that this one may shed further light on the relationship between mouth bacteria and other disorders. The research was written up in Microbiology Spectrum.
Previous research has shown direct connections between dental health and widespread illnesses like diabetes, cancer, cardiovascular disease, and Alzheimer's disease. Few longitudinal investigations have, however, been conducted to determine the specific bacteria present in infected oral- and maxillofacial areas.
Also Read | COVID-19 Vaccinated People Now Make Majority of Deaths in US: Report.
The most prevalent bacteria have been identified after an analysis of samples taken from patients with severe oral infections between 2010 and 2020 at the Karolinska University Hospital in Sweden by researchers at Karolinska Institutet.
This was a collaborative study that was performed by Professor Margaret Sallberg Chen and adjunct Professor Volkan Ozenci's research groups.
Also Read | Apple Partners With Epic Systems Offer Health Record Tool on macOS.
"We're reporting here, for the first time, the microbial composition of bacterial infections from samples collected over a ten-year period in Stockholm County," says Professor Sallberg Chen of the Department of Dental Medicine at Karolinska Institutet. "The results show that several bacterial infections with link to systemic diseases are constantly present and some have even increased over the past decade in Stockholm."
A role in other diseases
The study shows that the most common bacterial phyla amongst the samples were Firmicutes, Bacteroidetes, Proteobacteria and Actinobacteria, while the most common genera were Streptococcus spp, Prevotella spp, and Staphylococcus spp.
"Our results provide new insight into the diversity and prevalence of harmful microbes in oral infections," says Professor Sallberg Chen. "The finding isn't only of importance to dental medicine, it also helps us understand the role of dental infection in patients with underlying diseases. If a certain bacterium infects and causes damage in the mouth, it's very likely that it can be harmful to tissues elsewhere in the body as the infection spreads."
The research group has previously shown that the occurrence of oral bacteria in the pancreas reflects the severity of pancreatic tumours.
The study was conducted using 1,014 samples from as many patients, of whom 469 were women and 545 men, and a mass-spectrometric method called MALDI-TOF rapidly identifies individual living bacteria in a sample, but that is rarely used in dental care.
"Our study was a single centre epidemiology study and to ensure the validity of the results we need to make more and larger studies," says Volkan Ozenci at the Department of Laboratory Medicine, Karolinska Institutet. "We now hope that dentists will collaborate with clinical microbiology laboratories more to gain a better understanding of the bacteria that cause dental infections, to improve diagnostics and therapeutic management of oral infections." (ANI)
(The above story is verified and authored by ANI staff, ANI is South Asia's leading multimedia news agency with over 100 bureaus in India, South Asia and across the globe. ANI brings the latest news on Politics and Current Affairs in India & around the World, Sports, Health, Fitness, Entertainment, & News. The views appearing in the above post do not reflect the opinions of LatestLY)













 Quickly
Quickly